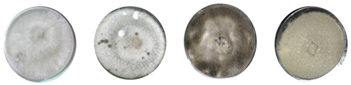
Microbiolres 16 00219 i001 Microbiolres 16 00219 i001

Phenotypic, Pathogenic, and Genetic Diversity of Botrytis cinerea Isolates from Moroccan Vineyards
Abstract
1. Introduction
2. Materials and Methods
2.1. Botrytis Cinerea Sampling and Morphological Identification
2.2. DNA Extraction
2.3. Molecular Confirmation
2.4. Morphological Diversity and Culture Conditions
2.5. Virulence Characterization of B. cinerea
2.6. Transposon Detection
2.7. Mating-Type Determination
2.8. Nuclear Gene Sequencing and Phylogenetic Analysis
2.9. Statistical Analysis
3. Results
3.1. Morphological and Molecular Identification of B. cinerea
3.2. Morphological and Cultural Diversity
3.3. Isolates’ Aggressivity
3.4. Transposable Element
3.5. Mating-Type Distribution
3.6. Phylogenetic Analysis
4. Discussion
5. Conclusions
Supplementary Materials
Author Contributions
Funding
Institutional Review Board Statement
Informed Consent Statement
Data Availability Statement
Conflicts of Interest
References
- Alfonso, C.; Raposo, R.; Melgarejo, P. Genetic Diversity in Botrytis cinerea Populations on Vegetable Crops in Greenhouses in South-Eastern Spain. Plant Pathol. 2000, 49, 243–251. [Google Scholar] [CrossRef]
- Elad, Y.; Williamson, B.; Tudzynski, P.; Delen, N. Botrytis: Biology, Pathology and Control; Springer Netherlands: Dordrech, 2007; ISBN 978-1-4020-2626-3. [Google Scholar]
- Dean, R.; Van Kan, J.A.L.; Pretorius, Z.A.; Hammond-Kosack, K.E.; Di Pietro, A.; Spanu, P.D.; Rudd, J.J.; Dickman, M.; Kahmann, R.; Ellis, J.; et al. The Top 10 Fungal Pathogens in Molecular Plant Pathology. Mol. Plant Pathol. 2012, 13, 414–430. [Google Scholar] [CrossRef] [PubMed]
- Williamson, B.; Tudzynski, B.; Tudzynski, P.; Van Kan, J.A.L. Botrytis cinerea: The Cause of Grey Mould Disease. Mol. Plant Pathol. 2007, 8, 561–580. [Google Scholar] [CrossRef]
- Jarvis, W. Botrytinia and Botrytis Species: Taxonomy, Physiology, and Pathogenicity, A Guide to the Literature; Canada Department of Agriculture: Ottawa, ON, Canada, 1977; Volume Monograph, ISBN D-662-00794-8. [Google Scholar]
- Paul, W.R.C. A Comparative Morphological and Physiological Study of a Number of Strains of Botrytis cinerea Pers. with Special Reference to Their Virulence. Trans. Br. Mycol. Soc. 1929, 14, 118–135. [Google Scholar] [CrossRef]
- Martinez, F.; Blancard, D.; Lecomte, P.; Levis, C.; Dubos, B.; Fermaud, M. Phenotypic Differences Between Vacuma and Transposa Subpopulations of Botrytis cinerea. Eur. J. Plant Pathol. 2003, 109, 479–488. [Google Scholar] [CrossRef]
- Rigotti, S.; Gindro, K.; Richter, H.; Viret, O. Characterization of Molecular Markers for Specific and Sensitive Detection of Botrytis cinerea Pers.: Fr. in Strawberry (Fragaria × Ananassa Duch.) Using PCR. FEMS Microbiol. Lett. 2002, 209, 169–174. [Google Scholar] [CrossRef]
- Fournier, E.; Giraud, T.; Albertini, C.; Brygoo, Y. Partition of the Botrytis cinerea Complex in France Using Multiple Gene Genealogies. Mycologia 2005, 97, 1251–1267. [Google Scholar] [CrossRef]
- Fournier, E.; Levis, C.; Fortini, D.; Leroux, P.; Giraud, T.; Brygoo, Y. Characterization of Bc-Hch, the Botrytis cinerea Homolog of the Neurospora crassahet-c Vegetative Incompatibility Locus, and Its Use as a Population Marker. Mycologia 2003, 95, 251–261. [Google Scholar] [CrossRef]
- Walker, A.-S.; Gautier, A.; Confais, J.; Martinho, D.; Viaud, M.; Le Pêcheur, P.; Dupont, J.; Fournier, E. Botrytis pseudocinerea, a New Cryptic Species Causing Gray Mold in French Vineyards in Sympatry with Botrytis cinerea. Phytopathology 2011, 101, 1433–1445. [Google Scholar] [CrossRef]
- Plesken, C.; Weber, R.W.S.; Rupp, S.; Leroch, M.; Hahn, M. Botrytis pseudocinerea Is a Significant Pathogen of Several Crop Plants but Susceptible to Displacement by Fungicide-Resistant B. cinerea Strains. Appl. Env. Microbiol. 2015, 81, 7048–7056. [Google Scholar] [CrossRef]
- Leroch, M.; Plesken, C.; Weber, R.W.S.; Kauff, F.; Scalliet, G.; Hahn, M. Gray Mold Populations in German Strawberry Fields Are Resistant to Multiple Fungicides and Dominated by a Novel Clade Closely Related to Botrytis cinerea. Appl. Env. Microbiol. 2013, 79, 159–167. [Google Scholar] [CrossRef]
- Fournier, E.; Giraud, T.; Loiseau, A.; Vautrin, D.; Estoup, A.; Solignac, M.; Cornuet, J.M.; Brygoo, Y. Characterization of Nine Polymorphic Microsatellite Loci in the Fungus Botrytis cinerea (Ascomycota). Mol. Ecol. Notes 2002, 2, 253–255. [Google Scholar] [CrossRef]
- Giraud, T.; Fortini, D.; Levis, C.; Leroux, P.; Brygoo, Y. RFLP Markers Show Genetic Recombination in Botryotinia Fuckeliana (Botrytis cinerea) and Transposable Elements Reveal Two Sympatric Species. Mol. Biol. Evol. 1997, 14, 1177–1185. [Google Scholar] [CrossRef] [PubMed]
- Paplomatas, E.J.; Pappas, A.C.; Antoniadis, D. A Relationship among Fungicide-resistant Phenotypes of Botrytis cinerea Based on RAPD Analysis. J. Phytopathol. 2004, 152, 503–508. [Google Scholar] [CrossRef]
- Staats, M.; Van Baarlen, P.; Van Kan, J.A.L. AFLP Analysis of Genetic Diversity in Populations of Botrytis Elliptica and Botrytis tulipae from the Netherlands. Eur. J. Plant Pathol. 2007, 117, 219–235. [Google Scholar] [CrossRef]
- Thompson, J.R.; Latorre, B.A. Characterization of Botrytis cinerea from Table Grapes in Chile Using RAPD-PCR. Plant Dis. 1999, 83, 1090–1094. [Google Scholar] [CrossRef]
- Johnston, P.R.; Hoksbergen, K.; Park, D.; Beever, R.E. Genetic Diversity of Botrytis in New Zealand Vineyards and the Significance of Its Seasonal and Regional Variation. Plant Pathol. 2014, 63, 888–898. [Google Scholar] [CrossRef]
- Diolez, A.; Marches, F.; Fortini, D.; Brygoo, Y. Boty, a Long-Terminal-Repeat Retroelement in the Phytopathogenic Fungus Botrytis cinerea. Appl. Env. Microbiol. 1995, 61, 103–108. [Google Scholar] [CrossRef]
- Levis, C.; Fortini, D.; Brygoo, Y. Flipper, a Mobile Fot1-like Transposable Element in Botrytis cinerea. Mol. Gen. Genet. 1997, 254, 674–680. [Google Scholar] [CrossRef]
- Giraud, T.; Fortini, D.; Levis, C.; Lamarque, C.; Leroux, P.; LoBuglio, K.; Brygoo, Y. Two Sibling Species of the Botrytis cinerea Complex, transposa and vacuma, Are Found in Sympatry on Numerous Host Plants. Phytopathology 1999, 89, 967–973. [Google Scholar] [CrossRef]
- Bergquist, R.R.; Lorbeer, J.W. Apothecial Production, Compatibility and Sex in Botryotinia squamosa. Mycologia 1972, 64, 1270–1281. [Google Scholar] [CrossRef]
- Faretra, F.; Antonacci, E.; Pollastro, S. Sexual Behaviour and Mating System of Botryotinia Fuckeliana, Teleomorph of Botrytis cinerea. Microbiology 1988, 134, 2543–2550. [Google Scholar] [CrossRef]
- De Miccolis Angelini, R.M.; Rotolo, C.; Pollastro, S.; Faretra, F. Molecular Analysis of the Mating Type (MAT 1) Locus in Strains of the Heterothallic Ascomycete Botrytis cinerea. Plant Pathol. 2016, 65, 1321–1332. [Google Scholar] [CrossRef]
- FAO FAOSTAT–Cultures et Produits Animaux. Available online: https://www.fao.org/faostat/fr/#data/QCL (accessed on 18 August 2025).
- OIV Statistiques Par Pays-Production et Superficie de Raisin Au Maroc. Available online: https://www.oiv.int/fr/what-we-do/data-discovery-report?oiv (accessed on 18 August 2025).
- Aoujil, F.; Litskas, V.; Yahyaoui, H.; El Allaoui, N.; Benbouazza, A.; Aziz, A.; Hafidi, M.; Habbadi, K. Sustainability Indicators for the Environmental Impact Assessment of Plant Protection Products Use in Moroccan Vineyards. Horticulturae 2024, 10, 473. [Google Scholar] [CrossRef]
- Conlon, B.H.; Schmidt, S.; Poulsen, M.; Shik, J.Z. Orthogonal Protocols for DNA Extraction from Filamentous Fungi. STAR Protoc. 2022, 3, 101126. [Google Scholar] [CrossRef]
- Muñoz, C.; Gómez Talquenca, S.; Oriolani, E.; Combina, M. Genetic Characterization of Grapevine-Infecting Botrytis cinerea Isolates from Argentina. Rev. Iberoam. Micol. 2010, 27, 66–70. [Google Scholar] [CrossRef] [PubMed]
- van Kan, J.; Duarte, J.; Dekkers, E.; Dyer, P.; Kohn, L.M. The Botrytis cinerea Mating Type Loci. In Proceedings of the 15th International Botrytis Symposium, Cadiz, Spain, 30 May–4 June 2010; p. 39. [Google Scholar]
- NM ISO 20837:2008; Microbiology of food and animal feeding stuffs — Polymerase chain reaction (PCR) for the detection of food-borne pathogens — General requirements and definitions. Service de Normalisation Industrielle Marocaine (SNIMA): Rabat, Morocco, 2008.
- Jakobija, I.; Bankina, B.; Klūga, A. Morphological Variability of Botrytis cinerea—Causal Agent of Japanese Quince Grey Mould. Agron. Res. 2020, 18, 433. [Google Scholar] [CrossRef]
- Pei, Y.; Tao, Q.; Zheng, X.; Li, Y.; Sun, X.; Li, Z.; Qi, X.; Xu, J.; Zhang, M.; Chen, H.; et al. Phenotypic and Genetic Characterization of Botrytis cinerea Population from Kiwifruit in Sichuan Province, China. Plant Dis. 2019, 103, 748–758. [Google Scholar] [CrossRef] [PubMed]
- Yousef, S.A.M.; Ali, A.M.; Elsherbiny, E.A.; Atwa, A.A. Morphological, Genetic and Pathogenic Variability among Botrytis cinerea Species Complex Causing Gray Mold of Strawberry. Physiol. Mol. Plant Pathol. 2024, 134, 102395. [Google Scholar] [CrossRef]
- Aouzal, S.; Krimi Bencheqroun, S.; Zelmat, L.; Mbasani-Mansi, J.; Zakari, Z.; Haggoud, A.; Gaboun, F.; Khayi, S.; Houmairi, H.; Mentag, R. Genetic Diversity and Population Structure of Moroccan Botrytis spp. Strains, Causing Chocolate Spot Disease in Faba Bean. Arch. Phytopathol. Plant Prot. 2022, 55, 761–772. [Google Scholar] [CrossRef]
- Ourras, S.; Elouark, M.; El Aymani, I.; Msairi, S.; Chliyeh, M.; Selmaoui, K.; Abdelaziz El Alaoui, M.; Mouden, N.; Touhami, A.O.; Douira, A. First Report of Botrytis cinerea on Saffron Corms in Morocco. In Advances in Bioinformatics and Biomedical Engineering; Mabrouki, J., Ed.; IGI Global: Hershey, PA, USA, 2025; pp. 165–180. ISBN 9798369394502. [Google Scholar]
- Sellal, Z.; Dahmani, J.; Benkirane, R.; Ouazzani Touhami, A.; Douira, A. Pathogenic Capacity of Botrytis cinerea on Leaves of Pyrus Mamorensis, an Endemic Tree of Mamora Forest in Morocco. AJB 2017, 2, 125–129. [Google Scholar] [CrossRef]
- Hammoumi, S.; Bentata, F.; Khalifi, H.; Karim, S.; Maafa, I.; Elwahab, F.; Gaboun, F.; Brhadda, N.; Ziri, R.; Labhilili, M. Molecular Identification and Characterization of Botrytis spp. from Strawberry in Morocco. from Strawberry in Morocco. 2025, 23, 494. [Google Scholar] [CrossRef]
- Steel, C.C.; Blackman, J.W.; Schmidtke, L.M. Grapevine Bunch Rots: Impacts on Wine Composition, Quality, and Potential Procedures for the Removal of Wine Faults. J. Agric. Food Chem. 2013, 61, 5189–5206. [Google Scholar] [CrossRef]
- Steel, C.C.; Schwarz, L.J.; Qiu, Y.; Schueuermann, C.; Blackman, J.W.; Clark, A.C.; Schmidtke, L.M. Thresholds for Botrytis Bunch Rot Contamination of Chardonnay Grapes Based on the Measurement of the Fungal Sterol, Ergosterol. Aust. J. Grape Wine Res. 2020, 26, 79–89. [Google Scholar] [CrossRef]
- Lopez Pinar, A.; Rauhut, D.; Ruehl, E.; Buettner, A. Effects of Bunch Rot (Botrytis cinerea) and Powdery Mildew (Erysiphe necator) Fungal Diseases on Wine Aroma. Front. Chem. 2017, 5, 20. [Google Scholar] [CrossRef]
- Mirzaei, S.; Mohammadi Goltapeh, E.; Shams-Bakhsh, M.; Safaie, N.; Chaichi, M. Genetic and Phenotypic Diversity among Botrytis cinerea Isolates in Iran. J. Phytopathol. 2009, 157, 474–482. [Google Scholar] [CrossRef]
- Lorbeer, J.W. Variation in Botrytis and Botryotinia. Biol. Botrytis 1980, 19–40. [Google Scholar]
- Achleitner, D. Investigations of Latent Infection of Grape Bunches with Botrytis cinerea. Ph.D. Thesis, Universität für Bodenkultur, Wien, Austria, 2008. [Google Scholar]
- Acosta Morel, W.; Marques-Costa, T.M.; Santander-Gordón, D.; Anta Fernández, F.; Zabalgogeazcoa, I.; Vázquez De Aldana, B.R.; Sukno, S.A.; Díaz-Mínguez, J.M.; Benito, E.P. Physiological and Population Genetic Analysis of Botrytis Field Isolates from Vineyards in Castilla y León, Spain. Plant Pathol. 2019, 68, 523–536. [Google Scholar] [CrossRef]
- Fernández Acero, F.J.; Carbú, M.; El-Akhal, M.R.; Garrido, C.; González-Rodríguez, V.E.; Cantoral, J.M. Development of Proteomics-Based Fungicides: New Strategies for Environmentally Friendly Control of Fungal Plant Diseases. IJMS 2011, 12, 795–816. [Google Scholar] [CrossRef] [PubMed]
- Kumari, S.; Tayal, P.; Sharma, E.; Kapoor, R. Analyses of Genetic and Pathogenic Variability among Botrytis cinerea Isolates. Microbiol. Res. 2014, 169, 862–872. [Google Scholar] [CrossRef] [PubMed]
- Zhang, Y.; Li, X.; Shen, F.; Xu, H.; Li, Y.; Liu, D. Characterization of Botrytis cinerea Isolates From Grape Vineyards in China. Plant Dis. 2018, 102, 40–48. [Google Scholar] [CrossRef]
- Campia, P.; Venturini, G.; Moreno-Sanz, P.; Casati, P.; Toffolatti, S.L. Genetic Structure and Fungicide Sensitivity of Botrytis cinerea Populations Isolated from Grapevine in Northern Italy. Plant Pathol. 2017, 66, 890–899. [Google Scholar] [CrossRef]
- DeLong, J.A.; Saito, S.; Xiao, C.-L.; Naegele, R.P. Population Genetics and Fungicide Resistance of Botrytis cinerea on Vitis and Prunus spp. in California. Phytopathology 2020, 110, 694–702. [Google Scholar] [CrossRef] [PubMed]
- Martinez, F.; Dubos, B.; Fermaud, M. The Role of Saprotrophy and Virulence in the Population Dynamics of Botrytis cinerea in Vineyards. Phytopathology 2005, 95, 692–700. [Google Scholar] [CrossRef]
- Wessels, B.A.; Linde, C.C.; Fourie, P.H.; Mostert, L. Genetic Population Structure and Fungicide Resistance of Botrytis cinerea in Pear Orchards in the Western Cape of South Africa. Plant Pathol. 2016, 65, 1473–1483. [Google Scholar] [CrossRef]
- Qiao, G.; Li, X.; Huang, J.; Lin, X.; Zhou, Y. Analysis and Molecular Detection of Botrytis cinerea Mating Type Genes. Mycosystema 2015, 34, 108–116. [Google Scholar]









| Phenotype | Mycelial Type | Sclerotial Type | ||||||
|---|---|---|---|---|---|---|---|---|
| M I | M II | M III | M IV | S I | S II | S III | S IV | |
| Mycelium | Short | Aerial | Mycelial masses | Thick and woolly | Rather short | Rather short | Rather short | Rather short |
| Sporulation | − | + | +/− | + | +/− | +/− | +/− | − |
| Sclerotia | 0 | - | - | - | In the edge of Petri dish | Often large, in circle | Often large, placed irregularly | Numerous small and scattered |
| Number of strains | 4 | 5 | 9 | 4 | 5 | 12 | 34 | 9 |
| Shape | ![]() | ![]() | ||||||
| Isolat_ID | Locality | Cultivar | Aggressivity | Morphotype | Mean_Sporearea (µm2) | Growth_Rate (mm d−1) | Mating_Type | Transposable_Element |
|---|---|---|---|---|---|---|---|---|
| BC01 | Boufekrane | Cinsault | High | Mycelial | 63.40 | 23.62 | - | Flipper_only |
| BC02 | Boufekrane | Cinsault | High | Sclerotial | 50.91 | 24.10 | MAT1-2 | Flipper_only |
| BC03 | El haj Kaddour | Muscat d’Italie | Medium | Sclerotial | 45.76 | 23.61 | MAT1-2 | Transposa |
| BC05 | Souk sabt jahjouh | Red globe | Low | Sclerotial | 55.94 | 22.41 | MAT1-2 | Vacuma |
| BC07 | Souk sabt jahjouh | Muscat d’Italie | Medium | Sclerotial | 43.67 | 20.09 | MAT1-2 | Transposa |
| BC08 | Ait Ouallal | Red globe | High | Mycelial | 35.59 | 21.71 | MAT1-2 | Flipper_only |
| BC11 | Ait Ouallal | Red globe | High | Sclerotial | 52.231 | 23.54 | MAT1-2 | Vacuma |
| BC12 | Souk El Gour | Red globe | High | Sclerotial | 56.66 | 23.54 | MAT1-2 | Boty_only |
| BC14 | Ait Ouallal | Red globe | High | Sclerotial | 10.67 | 23.00 | MAT1-2 | Vacuma |
| BC15 | Souk sabt jahjouh | Muscat d’Italie | Medium | Sclerotial | 49.93 | 23.04 | MAT1-2 | Transposa |
| BC16 | Souk sabt jahjouh | Red globe | Medium | Sclerotial | 41.31 | 22.74 | MAT1-1 | Transposa |
| BC18 | Ait Ouallal | Red globe | High | Mycelial | 43.99 | 23.67 | MAT1-2 | Flipper_only |
| BC21 | Douar laqsir | Aledo | High | Sclerotial | 41.21 | 23.89 | MAT1-1 | Transposa |
| BC24 | Douar laqsir | Aledo | High | Sclerotial | 34.75 | 23.12 | MAT1-1 | Transposa |
| BC46 | Souk sabt jahjouh | Muscat d’Italie | High | Sclerotial | 60.69 | 21.71 | MAT1-1 | Transposa |
| BC48 | Souk sabt jahjouh | Muscat d’Italie | Medium | Sclerotial | 64.87 | 23.81 | MAT1-2 | Vacuma |
| BC53 | Souk sabt jahjouh | Muscat d’Italie | High | Sclerotial | 54.10 | 22.97 | - | Vacuma |
| BC57 | Tiffelt | cardinal | High | Mycelial | 59.75 | 23.32 | MAT1-1 | Transposa |
| BC59 | Tiffelt | cardinal | Low | Sclerotial | 43.68 | 21.41 | MAT1-2 | Transposa |
| BC65 | Tiffelt | Red globe | Low | Sclerotial | 30.42 | 23.44 | MAT1-2 | Transposa |
| BC74 | Tiffelt | Red globe | High | Sclerotial | 54.66 | 22.29 | MAT1-2 | Boty_only |
| BC79 | Khemisset | Victoria | Medium | Mycelial | 65.44 | 22.92 | MAT1-2 | Vacuma |
| BC81 | Khemisset | Victoria | High | Mycelial | 57.04 | 23.53 | MAT1-2 | Vacuma |
| BC82 | Khemisset | Victoria | Medium | Mycelial | 61.96 | 23.09 | MAT1-2 | Boty_only |
Disclaimer/Publisher’s Note: The statements, opinions and data contained in all publications are solely those of the individual author(s) and contributor(s) and not of MDPI and/or the editor(s). MDPI and/or the editor(s) disclaim responsibility for any injury to people or property resulting from any ideas, methods, instructions or products referred to in the content. |
© 2025 by the authors. Licensee MDPI, Basel, Switzerland. This article is an open access article distributed under the terms and conditions of the Creative Commons Attribution (CC BY) license (https://creativecommons.org/licenses/by/4.0/).
Share and Cite
Aoujil, F.; El Ghdaich, C.; Hourmatallah, I.; Yahyaoui, H.; Hafidi, M.; Aziz, A.; Habbadi, K. Phenotypic, Pathogenic, and Genetic Diversity of Botrytis cinerea Isolates from Moroccan Vineyards. Microbiol. Res. 2025, 16, 219. https://doi.org/10.3390/microbiolres16100219
Aoujil F, El Ghdaich C, Hourmatallah I, Yahyaoui H, Hafidi M, Aziz A, Habbadi K. Phenotypic, Pathogenic, and Genetic Diversity of Botrytis cinerea Isolates from Moroccan Vineyards. Microbiology Research. 2025; 16(10):219. https://doi.org/10.3390/microbiolres16100219
Chicago/Turabian StyleAoujil, Faical, Chaimae El Ghdaich, Imane Hourmatallah, Hiba Yahyaoui, Majida Hafidi, Aziz Aziz, and Khaoula Habbadi. 2025. "Phenotypic, Pathogenic, and Genetic Diversity of Botrytis cinerea Isolates from Moroccan Vineyards" Microbiology Research 16, no. 10: 219. https://doi.org/10.3390/microbiolres16100219
APA StyleAoujil, F., El Ghdaich, C., Hourmatallah, I., Yahyaoui, H., Hafidi, M., Aziz, A., & Habbadi, K. (2025). Phenotypic, Pathogenic, and Genetic Diversity of Botrytis cinerea Isolates from Moroccan Vineyards. Microbiology Research, 16(10), 219. https://doi.org/10.3390/microbiolres16100219